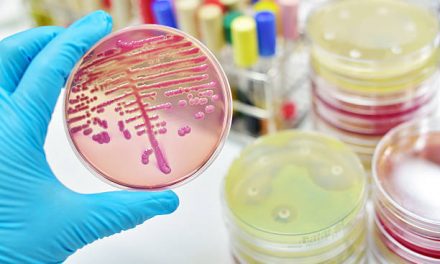

Health
PopularBetter sex through yoga
Yoga techniques are traditions of the Asian region. These methods have been investigated and exported to the west because of its proven health benefits to the human body and mind ...
Fitness
Top RatedPart 3 Break into Scuba Diving this Spring
You are then slowly guided upwards and sideways over the reef to explore more of the colors of the...
Medical
LatestAbout Osteochondritis Dissecans
Kimberly Allen R.N., Medical | 0 |
by Kimberly Allen, RN Osteochondritis dissecans or OCD is a relatively rare condition that affects...
Music
LatestMonochrome Twin Techno Pioneers of House music
Monochrome’s Rina & Rika: Tokyo’s twin engines of beautiful melodic techno and progressive...
All
Latest

Lose Those Extra Pounds
Dec 17, 2012

Curb Your Snacking Binges
Nov 15, 2012

Boost Your Metabolism, Naturally
Nov 15, 2012

Wondering Why Your Latest Fad Diet Isn...
Nov 15, 2012

Digestive Disorders Giving You Trouble?
Nov 7, 2012

Want Better Sex in your Marriage?
Nov 7, 2012

Why It’s Time To Hit The Fitness Club
Nov 7, 2012

How to make MOZZARELLA cheese
Nov 6, 2012

The Making of CHEESE
Nov 6, 2012

Is Homosexuality Caused By BPA Bisphenol...
Nov 2, 2012

Raw Is Good For You
Nov 2, 2012

Drink More Water
Oct 31, 2012

Keep Prostate Cancer At Bay
Oct 31, 2012

Teen Acne Problems?
Oct 29, 2012

Laughter Can Improve Your Health
Oct 29, 2012

Messi’s Powerful Legforce
Oct 26, 2012

10 Holiday Foods You Should Avoid
Oct 25, 2012

Honey Glazed Baked Ham Recipe
Oct 25, 2012

Medical Marijuana Initiatives in 2012: A...
Oct 25, 2012

Heart Surgery Recovery Plan
Oct 22, 2012

How Male Enhancers Can Shorten Your Life
Oct 22, 2012

Juicing It Right
Oct 22, 2012

Mashed Cauliflower Recipe
Oct 19, 2012

Oriental Beef Stir Fry Recipe
Oct 19, 2012

Beef Stew Recipe
Oct 19, 2012

How Well Do You Know Your Brain?
Oct 19, 2012

How To Turn Exercise into a Fitness Habi...
Oct 19, 2012

Eating Lunch Will Keep You Burning Calor...
Oct 19, 2012

Fungal Meningitis Found in Contaminated ...
Oct 18, 2012

How Legit Are These Vaccines?
Oct 15, 2012

Health Benefits of Snowboarding
Oct 11, 2012

Healthy Halloween Treats
Oct 10, 2012

Surfing The Fitness Waves
Oct 8, 2012

Super Foods For Kids
Oct 5, 2012

Quick And Fun Ways To Stay Fit
Oct 5, 2012

Are You Dying For A Cup Of Coffee?
Sep 21, 2012

Arsenic In Rice, Again?
Sep 20, 2012

Fall Fitness Tips
Sep 17, 2012

New York City’s Bans On Oversized ...
Sep 13, 2012

Bodybuilding Training At Home
Sep 13, 2012

Red Wine For Good Health?
Sep 13, 2012

The Roots Of Reflexology
Sep 13, 2012

Healthy Video Games
Sep 12, 2012

Short Guide To Fall Produce
Sep 11, 2012

Top Ways To Keep Your Mind Sharp
Sep 10, 2012

Pizza Can Be Good Or Bad For You
Sep 10, 2012

Love That “Runners High” Whe...
Sep 10, 2012

Wonders Of Coconut Oil
Sep 6, 2012

Greatest Health Quotes Ever
Sep 6, 2012

Good Fitness Ideas To Get You Back On Tr...
Sep 5, 2012

Healthy Benefits Of Fast Foods? NOT!!!
Sep 4, 2012

Where Does The USA Rank In Healthy Food ...
Sep 4, 2012

Do Vegans Get Enough Protein To Be Healt...
Sep 4, 2012

Is Wearing Jeans Good For Your Health?
Sep 1, 2012

Wake up Naturally Refreshed
Aug 31, 2012

Getting Ready For Emergency Situations
Aug 31, 2012

Give These healthy Oils A Try
Aug 30, 2012

Planning On taking The Kids Camping?
Aug 30, 2012

Cardio Benefits Of Bike Riding
Aug 28, 2012

How Football Players Stay In Shape
Aug 28, 2012

Stay More Focused At Work
Aug 27, 2012

Having A Hard Time Getting To Sleep?
Aug 27, 2012

Easy And Painless Workouts For College S...
Aug 27, 2012

Do You Wash Your New Clothes Before Wear...
Aug 24, 2012

Best Food For Good Fitness
Aug 24, 2012

Why Commercial Soap Is Bad For You And W...
Aug 24, 2012

What’s In That Microwave Popcorn?
Aug 23, 2012

Should You Bag Your Kids School Lunches?
Aug 23, 2012

Top Back To School Snacks
Aug 22, 2012

Your Type Of Foot Might Affect Your Work...
Aug 21, 2012

Dark Chocolate Raspberry Muffins
Aug 21, 2012

Dark Chocolate Breakfast
Aug 21, 2012

Why Are You Lactose Intolerant?
Aug 21, 2012

Back To School Diet For Dense Bones
Aug 20, 2012

Salt Is Good For You
Aug 16, 2012

Top 8 Sources Of Protein
Aug 16, 2012

Why Bran Is Good For You
Aug 15, 2012

The Greatness of Niacin (Vitamin B-3)
Aug 15, 2012

Naturally Boost Your Metabolism
Aug 15, 2012

Cleansing Your Colon Naturally
Aug 14, 2012

Staying Ahead Of Osteoporosis
Aug 14, 2012

The Healthy Power Of The Sun
Aug 14, 2012

Kid Friendly Snacks
Aug 8, 2012

Cheese facts
Aug 8, 2012

Beef Bourguignon recipe
Aug 4, 2012

Exercises To Get You Fit
Jul 31, 2012

Vegetables That Rock
Jul 31, 2012

Healthy and Refreshing Drink Alternative...
Jul 25, 2012

Wonderful herbal aids To Get You To Slee...
Jul 24, 2012

Are You Sleep Deprived?
Jul 24, 2012

The Soft Drink Controversy Continues
Jul 23, 2012

Being Overweight Ticking You Off?
Jul 23, 2012

Tiramisu Recipe
Jul 20, 2012

Eat Your Way to Recovery
Jul 19, 2012

What is a brain Stroke?
Jul 19, 2012

Get That Healthy Glow Back
Jul 19, 2012

Shrimp Wraps Recipe
Jul 18, 2012

Almond Raisin Fruit Balls recipe
Jul 18, 2012

Study Finds Almonds Great Against Diabet...
Jul 18, 2012

Facts On Cancer
Jul 18, 2012

Can Drinking Water Help Loss Weight?
Jul 18, 2012

Lower Your Cholesterol The Natural Way
Jul 18, 2012

The Great Benefits Of Chamomile
Jul 17, 2012

Working With Lighter Weights May Suffice
Jul 16, 2012

Figuring Out How to Eat Healthy getting ...
Jul 16, 2012

Smaller Bits of Food May Aid in Weight L...
Jul 16, 2012

Are Vaccines Really Good For You?
Jul 16, 2012

The Scoop on HFCS and non-alcoholic fatt...
Jul 15, 2012

Bottled Water Anyone?
Jul 11, 2012

The Unfreshness of Fresh Juice
Jul 11, 2012

Think Before Microwaving
Jul 11, 2012

Getting Your Kids To Exercise Right
Jul 2, 2012

Measuring Your Workout Intensity
Jul 2, 2012

Superfoods For Your Eyes
Jul 2, 2012

Basil is Great for Treating Diabetes
Jul 2, 2012

Muscle Cramps Bothering The Champion in ...
Jun 22, 2012

Maintain Your Happy and Healthy Eyes
Jun 22, 2012

Carpal Tunnel Syndrome
Jun 22, 2012

Minerals are Good For You
Jun 20, 2012

The health Wonders of Phytochemicals
Jun 20, 2012

Omega-3 fatty acids facts
Jun 20, 2012

Headache Bothering You?
Jun 14, 2012

The Importance of Eating Your Vegetables...
Jun 14, 2012

about Rosemary
Jun 11, 2012

Fighting Osteoporosis with Calcium Suppl...
Jun 11, 2012

Functions of Calcium
Jun 11, 2012

Making it Count with Super Brain-Healthy...
Jun 10, 2012

How to Look Younger
Jun 10, 2012

What’s Up With Mercury in our Food...
Jun 10, 2012

Omega 3 it To Reduce Inflammation
Jun 6, 2012

What is Metabolic Syndrome?
Jun 6, 2012

Causes and Treatment of Breast Cancer
Jun 6, 2012

Ways to Make Alkaline Diet Benefit You
Jun 4, 2012

Heart Healthy Diet
Jun 4, 2012

Fish Oil is Good for you
Jun 4, 2012

Medical Benefits from Shark Cartilage
Jun 2, 2012

Bee Pollen is Nature’s Most Complete Foo...
Jun 2, 2012

Causes and Treatment of Breast Cancer
Jun 2, 2012

Stretch Before You Work Out
May 4, 2012

shark oil is good for you but at what co...
May 4, 2012

Is Microwaved Food Really Healthy?
May 4, 2012

How Healthy and Fit is Facebook For You?
May 1, 2012

It is Easy Being Cheesy?
May 1, 2012

Bee Pollen and Royal Jelly Good For You?
Apr 23, 2012

Asian Food Best For Weight Loss
Apr 9, 2012

Best Foods for Burning Ugly Belly Fat
Apr 9, 2012

Basic Exercises To Get You Back In Shape
Apr 9, 2012

A Deeper look into The Latest Fruit Juic...
Apr 2, 2012

how Get Rid of Bad Breath
Apr 2, 2012

quit Caffeine For Good
Apr 2, 2012

Is Viagra Really Good For You?
Apr 2, 2012

Lunch Is the Key To Keeping Your Metabol...
Apr 2, 2012

To Juice Or Not To Juice
Apr 2, 2012

Understanding Vinyasa vs. Hatha Yoga
Mar 30, 2012

fantastic Tips for Dry Skin
Mar 27, 2012

Dangers of Comercial Sunscreens
Mar 27, 2012

Reason Why That Latest Diet May Not Be W...
Mar 27, 2012

Break into Scuba Diving this Spring part...
Mar 22, 2012

Break into Scuba Diving this Spring part...
Mar 22, 2012

Pasture Organic Grass Fed Beef is Good F...
Mar 19, 2012

Simply Kendi
Mar 16, 2012

Random and Informative Health Facts
Mar 15, 2012

Simple Steps For Better Digestion
Mar 15, 2012

Interesting Facts About Your Nails and H...
Mar 15, 2012

Cool Facts About Your Brain
Mar 15, 2012

Eat Your Veggies, Live Long
Mar 15, 2012

Crazy and Interesting Health Facts
Mar 15, 2012

how to Increase your Metabolism to Lose ...
Mar 9, 2012

delicious Food to Eat During an Injury
Mar 9, 2012

When to Choose Heat or Ice in a Sports I...
Mar 9, 2012

It’s Time to Detox That Liver
Mar 9, 2012

What is a Good Breakfast to Have?
Mar 9, 2012

Fun Ways to Turn Exercise into a Habit
Mar 9, 2012

Unhealthy Snacks are Damaging our Kids H...
Mar 9, 2012

Living Healthy Equals a Healthy Prostate
Mar 9, 2012

eat avocados to Loss Weight
Mar 9, 2012

What is a brain Stroke?
Mar 9, 2012

Artificial Sweeteners Will Damage your h...
Mar 9, 2012

Part 3 Break into Scuba Diving this Spri...
Mar 5, 2012

Part 2 Break into Scuba Diving this Spri...
Mar 5, 2012

Use phytochemical power with noni fruit
Mar 5, 2012

Part 1 Break into Scuba Diving this Spri...
Mar 5, 2012

How poverty effects diet and poor fitnes...
Mar 2, 2012

Kidney Good Foods
Mar 1, 2012

Truth about colon cancer
Feb 27, 2012

The greatest of all healing plants, Aloe...
Feb 27, 2012

Eating breakfast can keep you fit
Feb 27, 2012

Tips on Preventing Baldness
Feb 27, 2012

Top massage therapies
Feb 27, 2012

Music to heal the body and soul
Feb 27, 2012

Treat hypertension naturally
Feb 27, 2012

Alcohol and aging
Feb 22, 2012

how to get rid of leg cramps
Feb 22, 2012

Healthy skin tips
Feb 22, 2012

Common jogging errors
Feb 22, 2012

some good tips on detoxing yourself from...
Feb 22, 2012

Tips on treating flu and colds naturally
Feb 21, 2012

Hyperactivity caused in children due to ...
Feb 20, 2012

Cut your cholesterol with these easy tip...
Feb 17, 2012

Tai Chi is great for your heart
Feb 15, 2012

Unhealthy effects of loud music
Feb 15, 2012

Quick and easy ways to ease gas and bloa...
Feb 15, 2012

Tips to fix stomach ulcers
Feb 15, 2012

get rid of diarrhea naturally
Feb 15, 2012

Better breathing under stress means maki...
Feb 15, 2012

Super salad recipe
Feb 9, 2012

Quick ways to get your constipation fixe...
Feb 8, 2012

The American Dietetic Association soon t...
Feb 7, 2012

Eating energizing snacks can keep you go...
Feb 7, 2012

Top ways to boost your memory with the r...
Feb 2, 2012

Your eyes need a good workout too
Feb 2, 2012

great Diet for healthy skin
Feb 2, 2012

Quick and fit way to lower your blood pr...
Feb 1, 2012

Ice cold soda your drink of choice
Jan 31, 2012

your diet against Acid Reflux
Jan 30, 2012

What’s in that bottled water your drinki...
Jan 30, 2012

Pesticides in Monsanto’s cigarette tobac...
Jan 26, 2012

How safe is microwaved foods?
Jan 24, 2012

That freshly squeezed boxed OJ may not b...
Jan 23, 2012

Multiple Sclerosis may have simple cure
Jan 23, 2012

CDC states that Mothers should cease bre...
Jan 23, 2012

What’s in a mothers Breast milk?
Jan 23, 2012

Cancer drugs turn tumors into deadlier a...
Jan 19, 2012

Fun Health Facts to Think About
Jan 19, 2012

The ABCD’s of old age
Jan 18, 2012

wrist curls or not
Jan 18, 2012

dogs can be good for your health
Jan 9, 2012

3 Tips for a clean and glowing face
Jan 5, 2012

Hot Chicken Stew
Jan 5, 2012

Death in babies linked to infant formula
Jan 4, 2012

Natural ways to deter the winter blues w...
Jan 4, 2012

Just because you’re thin doesn’t mean yo...
Dec 28, 2011

Tips to alleviating that chesty cough
Dec 28, 2011

Find Us On Facebook
Dec 23, 2011

Do you suffer from excessive sweating?
Dec 21, 2011

Is your low testosterone level keeping y...
Dec 20, 2011

Green tea can reduce fat on your body
Dec 19, 2011

Top Headache Triggers
Dec 16, 2011

Boost your Health with the SUN
Dec 14, 2011

Fun Fitness Activities to Cure and Keep ...
Dec 14, 2011

Wanna live longer and have better sex? J...
Dec 13, 2011

Gingerbread Cookies
Dec 12, 2011

When’s the best time to get your protein...
Dec 11, 2011

Ginseng Facts
Dec 9, 2011

5 smart things to do when you are diagno...
Dec 6, 2011

Your metabolism and ways to boost it
Dec 5, 2011

6 Top ways to have fun and stay fit
Nov 29, 2011

Laughter: the best Therapy
Nov 28, 2011

Ayurveda for Treating Hypertension
Nov 23, 2011

Change up your workouts for fitness and ...
Nov 21, 2011

5 Reasons why Senior Citizens should do ...
Nov 17, 2011

What foods can help you fall asleep?
Nov 16, 2011

Lower your Stress with Food
Nov 16, 2011

Christmas Hot Apple Cider
Nov 15, 2011

Eggnog
Nov 15, 2011

Christmas Pecan Pie Recipe
Nov 15, 2011

Cranberry Sauce
Nov 15, 2011

Sex abuse scandal at Penn State Gets wor...
Nov 14, 2011

Self test to see if you are Hypoglycemic...
Nov 14, 2011

Are you having digestive disorders?
Nov 12, 2011

When is it a good time to check your Kid...
Nov 12, 2011

Penn State Sex Scandal
Nov 11, 2011

Up you Calcium intake Lower your chances...
Nov 10, 2011

Choosing the Right Deodorant that will n...
Nov 10, 2011

How the Sun Effects our Emotions
Nov 9, 2011

Boost your Health with Tai Chi
Nov 9, 2011

Healthy Antioxidant Benefits of Tea
Nov 9, 2011

Easy Tips to Help You Deal with Arthriti...
Nov 8, 2011

5 ways to Prevent Alzheimer’s
Nov 8, 2011

Want whiter teeth?
Nov 5, 2011

Halliburton is sued over Cold War missil...
Nov 5, 2011

How Diet affects the Hair
Nov 4, 2011

Green Bean Casserole
Nov 3, 2011

Tips to getting a Better Night’s Sleep T...
Nov 3, 2011

Healthy Tips for Staying Sniffle-Free Th...
Nov 1, 2011

Change Your Attitude with Aromatherapy
Oct 31, 2011

Five Underrated Movements
Oct 27, 2011

What is Good Posture and How to Maintain...
Oct 20, 2011

The Nature of Sleep Apnea
Oct 20, 2011

Free Range Chicken Eggs Better than Soy ...
Oct 12, 2011

Don’t Blame Testosterone for Prost...
Oct 4, 2011

Acne Prevention Tips for Teens
Oct 2, 2011

Monochrome Twin Techno Pioneers of House...
Oct 16, 2025

Crack Cocaine’s Inner City Aftersh...
Oct 15, 2025

About Us
Oct 5, 2025

Reaching Your Goal Physique Part 1 ̵...
Jul 23, 2014

Working Out Before Work For Women
Jul 17, 2014

How To Fix Muscle Imbalances
Feb 26, 2014

V-Shape – The Perfect Body Shape
Feb 26, 2014

Monsanto’s Bee Problem Fix? GM Bee...
Feb 24, 2014

Why the FDA Ban on Trans Fats is The Bes...
Jan 22, 2014

Take Your Training To The Next Level ...
Jan 7, 2014

A Caution About Kettlebell Workouts
Jan 7, 2014

The Health and Fitness Talk 2014 Resolut...
Jan 4, 2014

How To Live Longer & Live Better Sen...
Dec 12, 2013

About Osteochondritis Dissecans
Dec 12, 2013

Don’t Be Fooled By Food Substitute...
Dec 6, 2013

Osgood-Schlatter Disease
Dec 4, 2013

Health Benefits For Pets
Nov 20, 2013

Building Muscles With Yoga
Nov 20, 2013

Pregnancy Exercises To Get You Going
Nov 20, 2013

Knee Injury Issues
Nov 19, 2013

Managing Your Liver Disease Naturally
Nov 14, 2013

GMO Update: Labeling Law Defeated in Was...
Nov 12, 2013

Healthy Tips To Avoid Osteoporosis
Nov 12, 2013

Your Calorie Counting Health Turnaround
Nov 12, 2013

Childhood Obesity
Nov 12, 2013

Primary Biliary Cirrosis
Nov 12, 2013

Vitiligo
Nov 12, 2013

Halloween – The Most Harmful Holid...
Oct 30, 2013

How To Safely CAN Your Own Garden Vegeta...
Oct 29, 2013

Rafting – A Great Exercise Experie...
Oct 23, 2013

Autoimmune Disorders
Oct 23, 2013

Never Too Late To Start Working Out
Oct 18, 2013

How to Recover From a Foot Injury
Oct 18, 2013

Yoga Body Postures
Oct 11, 2013

Skiing For Exercise
Oct 11, 2013

Hydronephrosis
Oct 11, 2013

Avoiding Stretch Marks
Oct 11, 2013

GMO Update: Victory!
Oct 5, 2013

FDA Approval a Trojan Horse for Big Phar...
Sep 30, 2013

Chocolate Nutella Cake Recipe
Sep 27, 2013

Exercises For A Sprained Ankle
Sep 25, 2013

Getting The Best Bargain Out Of Your Wor...
Sep 25, 2013

Four Minute Muscle Builders
Sep 25, 2013

5 Tips To Reverse Your Aging
Sep 25, 2013

Extreme Workout Plan
Sep 25, 2013

Exercises That Feel Left Out
Sep 25, 2013

Maintaining Healthy Joints
Sep 25, 2013

Do You Have A Leaky Gut?
Sep 24, 2013

20 Minutes of Glory – All The Exer...
Sep 23, 2013

Tips For Early Morning Exercise
Sep 23, 2013

How To Stay Motivated to Workout in Wint...
Sep 23, 2013

Exercise and Academic Progress
Sep 23, 2013

Erythema multiforme
Sep 23, 2013

Healthy Shopping
Sep 23, 2013

More on Yoga: Reducing Stress Through Ba...
Sep 23, 2013

The Health Benefits of a Green Thumb
Sep 23, 2013

Loosing 40 lbs By Counting – Calor...
Sep 23, 2013

5 Steps To Lean And Toned Arms
Sep 18, 2013

How To Build Your Metabolism
Sep 18, 2013

Partner Exercising
Sep 18, 2013

Flowing Yoga Into Your Arteries
Sep 18, 2013

Exercises For A Healthy Heart
Sep 17, 2013

Triceps – The Strength Behind A Pu...
Sep 17, 2013

Tips For A Better Workout Plan
Sep 17, 2013

The Dangers Of Acetaminophen
Sep 17, 2013

Effects Of Positive Thinking On Your Hea...
Sep 17, 2013

Tangier Disease
Sep 17, 2013

Managing IBD With Diet
Sep 17, 2013

The Changing View On Vaccinations Part 2
Sep 16, 2013

Ulcerative Colitis
Sep 16, 2013

Maintaining Manners At The Gym
Sep 16, 2013

Maintaining The Benefits Of Exercise
Sep 16, 2013

Fitness For Cancer Patients
Sep 16, 2013

Paget’s Disease
Sep 12, 2013

Charcot-Marie-Tooth – CMT
Sep 12, 2013

Hydrocephalus
Sep 12, 2013

Kennedy Disease
Sep 12, 2013

Exercising With Arthritis
Sep 12, 2013

Baseball Training Workouts
Sep 12, 2013

Kick And Punch Your Way To Fitness
Sep 12, 2013

Can Video Games Make You Fit?
Sep 12, 2013

Indoor Wall Climbing
Sep 12, 2013

Cauda Equina Syndrome
Sep 11, 2013

Medical Marijuana And Dravet Syndrome
Sep 11, 2013

Treat Back Pain The Right Way
Sep 11, 2013

Pilates Exercises
Sep 11, 2013

Hate Exercising?
Sep 11, 2013

Muscle Group Workouts For Total Fitness
Sep 9, 2013

Three Fitness Dances
Sep 9, 2013

Bodyweight Exercises And Supplements
Sep 9, 2013

Exercises For Rainy Days
Sep 9, 2013

What To Look For In Fitness Fashion and ...
Sep 6, 2013

Get Jail Buff – Prison-Oriented Wo...
Sep 6, 2013

Exercises For The Whole Family
Sep 4, 2013

Sexy legs
Sep 4, 2013

Fitness Personalities
Sep 4, 2013

Yoga For a Better Sex Life and Healthier...
Sep 4, 2013

Exercise: A Good Dose of Medicine for th...
Sep 4, 2013

A Fitness-Based Relationship
Sep 4, 2013

Bodybuilding For Women
Sep 4, 2013

Be Motivated and Make Your Workout a Pri...
Aug 30, 2013

Common Workout Injuries
Aug 30, 2013

Herniated Disc
Aug 30, 2013

Friedreich’s Ataxia
Aug 28, 2013

Jewish Inherited Diseases: Tay-Sachs and...
Aug 28, 2013

Maintaining Physical Fitness
Aug 28, 2013

Lean or Bulky Muscles?
Aug 28, 2013

Teen Pregnancy
Aug 28, 2013

The Importance of Prenatal Care
Aug 26, 2013

Limbic Encephalitis
Aug 26, 2013

Choosing The Right Workout
Aug 21, 2013

Workouts For Healing a Hamstring Injury
Aug 21, 2013

15 Minute Workouts
Aug 21, 2013

Recover From Your First Workout
Aug 21, 2013

Exercising At Home
Aug 21, 2013

Calorie Counting – Part 1
Aug 20, 2013

The Key To Longevity Is….
Aug 20, 2013

What is NASH?
Aug 20, 2013

Amnesia Defined
Aug 20, 2013

Chanca Piedra – The Amazon’s...
Aug 20, 2013

Treating Cancer Naturally
Aug 20, 2013

Basketball – A Complete Workout
Aug 20, 2013

Get off The Couch, and Kick The Ball
Aug 20, 2013

The Brain Eating Amoeba
Aug 20, 2013

Kidney Stones and How To Treat Them Natu...
Aug 15, 2013

Cardio Strength Training
Aug 15, 2013

Are You Seeing Spots?
Aug 15, 2013

Get Ready For Female Football!
Aug 13, 2013

Fit Hips and Glutes
Aug 13, 2013

Diet and Workout Advice For Workaholics
Aug 13, 2013

Bored With Your Routine? Try New Ideas
Aug 13, 2013

Yoga – The Perfect Pregnancy Worko...
Aug 13, 2013

Muscle Mass – When Weight Gain is ...
Aug 13, 2013

Avoid Excess Exercise
Aug 13, 2013

Choose The Right Workout
Aug 13, 2013

Sex – Key To A Younger You
Aug 12, 2013

Lack of Exercise
Aug 12, 2013

Fragile X and Klinefelter Syndromes
Aug 12, 2013

Paddleboarding – The Stand-Up Way ...
Aug 12, 2013

Using Sport and Medicine Balls For Your ...
Aug 12, 2013

Heat-Related Illnesses
Aug 12, 2013

Basketball Drills
Aug 12, 2013

Scavenger Fitness Hunt
Aug 8, 2013

Rock Out Your Workouts
Aug 8, 2013

Towel Exercises
Aug 8, 2013

Postpartum Depression
Aug 7, 2013

Breast or Bottle?
Aug 7, 2013

Hiking Yoga
Aug 7, 2013

Surf Set Fitness
Aug 7, 2013

Functional Fitness
Aug 7, 2013

The Changing View on Vaccinations
Aug 7, 2013

Cinnamon and Honey
Aug 6, 2013

Birth Defects
Aug 6, 2013

X-linked Adrenoleukodystrophy
Aug 6, 2013

Single-Celled Parasites – Toxoplas...
Aug 6, 2013

Energy and The Magnesium Connection
Aug 6, 2013

How The Farm Bill Makes The U.S. Fat, Bu...
Jul 19, 2013

Testicular Cancer
Jul 19, 2013

Cervical Cancer
Jul 19, 2013

Botox – For More Than Just Wrinkle...
Jul 19, 2013

End Stage Renal Disease
Jul 17, 2013

About Amyloidosis
Jul 17, 2013

Cardiomyopathy
Jul 17, 2013

Kranking
Jul 17, 2013

Aqua Cycling
Jul 17, 2013

Garcinia Cambogia Extract – Miracl...
Jul 16, 2013

Mountain Fitness
Jul 15, 2013

Posterior Urethral Valves
Jul 15, 2013

Chronic Kidney Disease
Jul 15, 2013

CrossFit Training
Jul 15, 2013

The Charley Horse Cramp
Jul 15, 2013

Martial Arts Fusion Classes
Jul 15, 2013

Brain-Based Exercise
Jul 15, 2013

The Asian Tiger Mosquito and Chikungunya...
Jul 15, 2013

Sudden Combined Immunodeficiency Disorde...
Jul 15, 2013

Early Morning Workout
Jul 15, 2013

Tai-Chi
Jul 12, 2013

Working Out At Work
Jul 12, 2013

Beach Workouts
Jul 12, 2013

A Body Fit To Box
Jul 12, 2013

Aqua Zumba
Jul 11, 2013

Fitness Parties
Jul 11, 2013

Nordic Walking For a Stronger You!
Jul 10, 2013

Rett Syndrome
Jul 10, 2013

Gene Therapy – Medicine’s Fu...
Jul 10, 2013

Duchenne Muscular Dystrophy
Jul 10, 2013

DiGeorge Syndrome
Jul 10, 2013

Tetralogy of Fallot (TOF)
Jul 10, 2013

Neurofibromatosis
Jul 10, 2013

Auditory Brainstem and Cochlear Implants
Jul 10, 2013

Kawasaki Disease
Jul 10, 2013

Five Tips to a Flat Tummy
Jun 30, 2013

Bladder Cancer
Jun 28, 2013

Addison’s Disease
Jun 28, 2013

The Bad Plan B – An Over-The-Count...
Jun 28, 2013

Krabbe Disease
Jun 28, 2013

Graves Disease
Jun 28, 2013

New York Handball: The Sport For a Great...
Jun 28, 2013

Fitness Online
Jun 28, 2013

Try an Old-School Workout
Jun 28, 2013

Mental Fitness
Jun 28, 2013

Maintaining a Motivated Workout
Jun 28, 2013

Dance Workouts That Will Salsa You Skinn...
Jun 27, 2013

Muscle Specific Workouts
Jun 27, 2013

Recipes For Sexier Abs
Jun 27, 2013

Calisthenics: A simple and affordable wa...
Jun 27, 2013

Bike Sharing – Public Transportati...
Jun 21, 2013

Porphyrias
Jun 21, 2013

about Hemophilia
Jun 21, 2013

Polymorphous Light Eruption – Sun ...
Jun 21, 2013

Thrombocytopenia
Jun 21, 2013

about Hemorrhoids
Jun 21, 2013

Outdoor Workouts – Fun, Fit and Fr...
Jun 18, 2013

Pelvic Organ Prolapse
Jun 18, 2013

Celery Is Not An Empty Food
Jun 18, 2013

Raspberry Ultra Drops – Science or...
Jun 18, 2013

About Neuroblastoma
Jun 18, 2013

Are The Rules Fair?
Jun 18, 2013

New Virus Has World Health Organization ...
Jun 18, 2013

About Preeclamsia
Jun 18, 2013

Obstacle Races Are Fitness Fun
Jun 14, 2013

Stem Cells – The Future of Treatin...
Jun 13, 2013

Is Laser Eye Surgery Right For You?
Jun 13, 2013

The Flaw in Meat/Cancer Studies
Jun 13, 2013

Curing Candida Naturally
Jun 13, 2013

Dirty Bulking – Not As Dirty As Yo...
Jun 11, 2013

A Breakfast For Balanced Energy
Jun 7, 2013

GMO UPDATE: Peaceful Protests, Threats o...
Jun 7, 2013

The Breast Cancer Gene
Jun 4, 2013

How to Prevent Skin Cancer
Jun 4, 2013

about Pulmonary Fibrosis
Jun 3, 2013

About Lyme Disease
Jun 3, 2013

about Farmer’s Lung
Jun 3, 2013

Intermittent Claudication
Jun 3, 2013

about Narcissism
May 28, 2013

Fight Back Mosquito-Borne Illness This S...
May 28, 2013

About Stockholm Syndrome
May 28, 2013

about Spondyloarthropathis
May 28, 2013

Let The Frankenfish Go Extinct
May 23, 2013

GAPS – Bridging Diet and Psycholog...
May 21, 2013

Prevent Allergy Symptoms Without Drugs
May 16, 2013

Training Your Brain to Stay Fit
May 16, 2013

The Pros and Cons of a High Fiber Diet
May 16, 2013

Why We Need to March Against Monsanto
May 14, 2013

about Psoriatic Arthritis
May 10, 2013

Salmonella Cases on the Rise
May 10, 2013

about Folliculitis
May 10, 2013

Traumatic Limb Amputation
May 10, 2013

The Sweet Benefits of Kicking Sugar Addi...
May 8, 2013

Glutathione – Master Anti-Oxident
May 8, 2013

The Truth About All Those Red Meat Studi...
May 7, 2013

Faking The Organic Food Fraud
May 2, 2013

Green Coffee Bean Extract
May 2, 2013

Don’t Waste Rx
May 2, 2013

You Too Can Save a Life
May 2, 2013

about Uterine Fibroids
May 2, 2013

about Epstein-Barr Virus
Apr 29, 2013

about Burkitt’s Lymphoma
Apr 29, 2013

about Tumor Lysis Syndrome
Apr 29, 2013

Building Strength, Size, Endurance with ...
Apr 26, 2013

Nothing to Cramp About!
Apr 25, 2013

The Power of Cranberries
Apr 25, 2013

Detox the Proper Way!
Apr 25, 2013

Confronting Local Ordinances Over Vegeta...
Apr 25, 2013

Acute Renal Failure
Apr 23, 2013

Benefits of Probiotics
Apr 23, 2013

ADHD Drug Abuse Among Students
Apr 23, 2013

Prescription Drug Abuse on the Rise
Apr 22, 2013

Make Friends, Live Longer
Apr 22, 2013

The New Bird Flu
Apr 22, 2013

Juvenile Rheumatoid Arthritis and New Tr...
Apr 22, 2013

Recover From Injury The Right Way
Apr 19, 2013

about Angina
Apr 15, 2013

Multiple Endocrine Neoplasia
Apr 15, 2013

Pituitary Gland Tumors
Apr 15, 2013

A Nightmare Dentist Office
Apr 15, 2013

Spina Bifida and Encephaloceles
Apr 15, 2013

Cabin Fever
Apr 15, 2013

The Cannabis Cure for Cancer
Apr 11, 2013

Glutamine: An Incredibly Important Condi...
Apr 9, 2013

Tibial Stress Syndrome, Shin Splints
Apr 8, 2013

Peptic Ulcer Disease
Apr 8, 2013

about Ciguatera
Apr 8, 2013

WANTED: Blood Donors
Apr 8, 2013

about Celiac Disease
Apr 8, 2013

When To Start Baby on Solid Food
Apr 8, 2013

Death By Rabies Highlights Organ Donor F...
Apr 8, 2013

Lebers Congenital Amaurosis (LCA)
Apr 8, 2013

about Gallstones
Apr 8, 2013

about Sickle Cell Disease
Apr 8, 2013

ABOUT Prostrate Cancer
Apr 8, 2013
Fungal Meningitis Outbreak Still Going S...
Apr 8, 2013

Flatten That Tummy with Quick and Easy S...
Apr 5, 2013

Easy Ways to Shed Unwanted Fat
Apr 4, 2013

Robin Williams Snickers Ads are Bad for ...
Apr 4, 2013

The Very Real Ramifications of The Monsa...
Apr 2, 2013

about Lung Cancer
Mar 26, 2013

about Leptomeningeal Carcinomatoisis
Mar 26, 2013

Daylight Savings’ Effect on Your H...
Mar 26, 2013

about Barrett’s Esophagus
Mar 26, 2013

Packrat or Hoarder?
Mar 26, 2013

Hearing Loss is on the Rise
Mar 26, 2013

Supplements Are No Substitute for a Heal...
Mar 26, 2013

Nightmare Bacteria
Mar 26, 2013

about Scabies
Mar 26, 2013

about Gliomas
Mar 26, 2013

Top 3 Fit Places to go this Easter Break
Mar 25, 2013

How to Naturally Lower your Blood Sugar ...
Mar 22, 2013

Discussing Raw Milk with Organic Pasture...
Mar 20, 2013

Does Exercise Help or Worsen your Arthri...
Mar 18, 2013

GMO Update: Whole Foods, Hawaii and Verm...
Mar 13, 2013

Failure to Thrive in Elderly
Mar 12, 2013

Preparing Your Seafood the Right Way
Mar 11, 2013

The Truth about Artificial Sweeteners!
Mar 11, 2013

Diet Soda and Alcohol
Mar 8, 2013

Anthrax Flashback
Mar 8, 2013

Largest TB Outbreak in Decade Among Home...
Mar 7, 2013

The Fear Response
Mar 7, 2013

about Medulloblastaboomas
Mar 7, 2013

is Bipolar Disorder Real?
Mar 7, 2013

The Nuts and Bolts of the Mediterranean ...
Mar 6, 2013

Prevent Cancer with Popcorn!
Mar 6, 2013

Meningiomas
Mar 5, 2013

Diabetic Retinopothy
Mar 4, 2013

Dyssautonomia
Mar 4, 2013

Restless Leg Syndrome
Mar 4, 2013

Sudden Infant Death Syndrome
Mar 4, 2013

Fun And Interesting Fitness and Health F...
Mar 1, 2013

Easy Ways to Ease Gas and Bloating
Mar 1, 2013

Sudden Cardiac Arrest
Feb 28, 2013

Bell’s Palsy
Feb 28, 2013

Neurofibromatosis
Feb 28, 2013

Milk – It Does a Body Bad?
Feb 27, 2013

Acoustic Neuromas
Feb 25, 2013

Acne
Feb 25, 2013

Meniere Disease
Feb 25, 2013

Stasis Ulcers
Feb 25, 2013

Maggot Therapy
Feb 25, 2013

The Bad News About Sugar
Feb 25, 2013

Flesh Eating Bacteria
Feb 25, 2013

Fresh Drinks that can Get Your Day Start...
Feb 25, 2013

“Honest” Coke Ad Blasts Comp...
Feb 25, 2013

Extreme Health Risk of Extreme Obesity
Feb 21, 2013

Alopecia
Feb 21, 2013

Loosing Sleep? Blame it on the Month
Feb 21, 2013

PTSD’s Lasting Effects
Feb 21, 2013

Three Surefire Ways to Stay Fit Focused
Feb 21, 2013

The Viciousness of Visceral Fat
Feb 14, 2013

The Importance of Hydration
Feb 14, 2013

Hip Fractures
Feb 12, 2013

Carbon Monoxide Poisoning
Feb 12, 2013

Grass-Fed Beef – Not Horsing Aroun...
Feb 11, 2013

The Common Cold Cure All – Chicken...
Feb 8, 2013

Flu or Norovirus?
Feb 7, 2013

Transient Ischemic Attacks
Feb 7, 2013

About aphasia
Feb 7, 2013

Learning Disabilities and Learning Disor...
Feb 6, 2013

The Myths of University of Alabama, Birm...
Feb 6, 2013

What is PBA? pseudobulbar affect disorde...
Feb 5, 2013

Chamomile’s Medical Benefits
Feb 5, 2013

Eat Your Way to Good Mental health
Feb 5, 2013

Antisocial Personality Disorders
Feb 5, 2013

The NFL and CTE
Jan 31, 2013

Personality Disorders
Jan 29, 2013

Flu Update: Now It’s an Epidemic
Jan 29, 2013

Acute Promyelocytic Leukemia
Jan 29, 2013

The Case For Preventative Care
Jan 29, 2013

Nutritional Knowledge Every Athlete Shou...
Jan 28, 2013

Oropharangeal Cancer
Jan 28, 2013

HPV-Related Cancers on the Rise Despite ...
Jan 28, 2013

ACL Injury
Jan 28, 2013

Pancreatic Cancer
Jan 28, 2013

How Periodontal Diseases Effect Your Ove...
Jan 28, 2013

The Magic of Mushrooms
Jan 28, 2013

A Serious Cry For Help
Jan 28, 2013

Make Nuts a Part of Your Diet
Jan 28, 2013

The Causes of Addiction
Jan 24, 2013

Hiatal Hernia
Jan 24, 2013

Heartburn
Jan 24, 2013

The State of Mental Health Care
Jan 24, 2013

Dairy Debates
Jan 24, 2013

The Truth About Diet Soda
Jan 24, 2013

Trauma and Children
Jan 24, 2013

FDA Approval a Trojan Horse for Herbal S...
Jan 24, 2013

Don’t Just Stop Bad Habits, Start ...
Jan 15, 2013

Why You Should Avoid Trans Fats
Jan 15, 2013

Is It a Cold or Winter Allergies?
Jan 15, 2013

Flu Season Arrives Early
Jan 15, 2013

Effects of Alcohol on Athletes
Jan 15, 2013

Diving With Kids and Teenagers
Jan 15, 2013

Best Techniques To Get Close To Marine L...
Jan 15, 2013

Massage and Migraines
Jan 15, 2013

Night Diving – A Different World
Jan 15, 2013

The Facts on Massaging Away Cellulite
Jan 11, 2013

Flu Epidemic Sweeps the Nation
Jan 11, 2013

Three Simple Rules for Weight Loss
Jan 10, 2013

Deadly Domestic Violence
Dec 28, 2012

Suicide – A Serious Public Health ...
Dec 28, 2012

Breaking Bad Habits
Dec 28, 2012

Do Cell Phones Really Cause Cancer?
Dec 28, 2012

The Power of Onions
Dec 28, 2012

Be Resolute – Quit Smoking
Dec 28, 2012

Nanomedicine – The Medicine of the...
Dec 28, 2012

Spinal Muscle Atrophy
Dec 21, 2012

about Sinusitis
Dec 21, 2012

The Reverse Pyramid Training Philosophy
Dec 21, 2012

Croup
Dec 18, 2012

Managing Holiday Stress
Dec 18, 2012

Respiratory Syncytial Virus (RSV)
Dec 18, 2012

Complications From Seasonal Flu
Dec 18, 2012

Dehydration
Dec 18, 2012

How Safe Are Energy Drinks?
Dec 18, 2012

Steer Clear of Trans Fats
Dec 18, 2012

‘Tis the Season for Holiday Heart ...
Dec 17, 2012

How Monsanto might trick Congress into g...
Dec 17, 2012

Calories And Mood
Dec 17, 2012

Tips For Diabetics
Dec 17, 2012

Prevent Heart Disease
Dec 17, 2012

New Years Resolutions to Join the Gym
Dec 17, 2012

Healthy Holiday Foods
Dec 13, 2012

Pertussis, a.k.a The Whooping Cough
Dec 13, 2012

Parasomnias
Dec 13, 2012

Snoring
Dec 13, 2012

Getting Your Children To Sleep
Dec 10, 2012

Narcolepsy
Dec 10, 2012

Insomnia
Dec 10, 2012

How to Use Fins Underwater the Right Way
Dec 4, 2012

The Importance of Marine Protected Areas
Dec 4, 2012

Easing Injury Through Massage
Nov 30, 2012

Tips to Prevent Winter Skin Problems
Nov 30, 2012

Febrile Seizures
Nov 30, 2012

Sydenham’s Chorea
Nov 29, 2012

Does Your Child Need a Tonsillectomy?
Nov 29, 2012

Massage and Fibromyalgia – Part of...
Nov 29, 2012

Acute Tonsillitis
Nov 29, 2012

Impetigo
Nov 29, 2012

Scarlet Fever
Nov 29, 2012

Rheumatic Fever
Nov 29, 2012

Strep Throat
Nov 29, 2012

Eating Disorders
Nov 28, 2012

about Gangrene
Nov 28, 2012

Sjogren’s Syndrome
Nov 28, 2012

about Scleroderma
Nov 27, 2012

Soothe Sciatica Away with Massage
Nov 27, 2012

The Chair Massage
Nov 27, 2012

Raynaud’s Phenomenom
Nov 27, 2012

PVD and PAD
Nov 27, 2012

Massaging the Elderly
Nov 26, 2012

Tackling Sports Injuries
Nov 26, 2012

Do You Have a Food Allergy or Food Intol...
Nov 26, 2012

Lactose Intolerance
Nov 26, 2012

Weston Meets for Annual Wise Traditions ...
Nov 19, 2012

The Spiritual Healing of Lomi-Lomi Hawai...
Nov 14, 2012

Celiac Disease
Nov 13, 2012

Sarcoidosis
Nov 13, 2012

Typhoid Fever
Nov 13, 2012

Rabies
Nov 13, 2012

Ehlers-Danlos Syndrome
Nov 13, 2012

Noonan Syndrome
Nov 13, 2012

Hypoglycemia and Hyperglycemia
Nov 13, 2012

Massage and Pregnancy
Nov 6, 2012

My First Client’s First Healing To...
Nov 6, 2012

Malaria
Nov 6, 2012

Dengue Fever
Nov 6, 2012

Health and Safety Tips for Winter
Nov 6, 2012

Hypothermia and Frostbite
Nov 6, 2012

Seasonal Affective Disorder
Nov 6, 2012

The Importance of Stress Management
Nov 6, 2012

The Myth of Man-opause
Nov 6, 2012

Sports Massage – The Original Perf...
Nov 2, 2012

Natural and Alternative Treatments for M...
Nov 2, 2012

Menopause
Nov 2, 2012

Domestic Violence: A Women’s Healt...
Nov 2, 2012

Busting Myths About GMO Labeling Laws
Oct 31, 2012

Your Kids Should Exercise
Oct 31, 2012

Aromatherapy Can Heal
Oct 29, 2012

Postpartum Depression
Oct 22, 2012

PMS or PMDD?
Oct 22, 2012

Massaging Giancarlo – Massage and ...
Oct 22, 2012

Why Do Women’s Health Issues Matte...
Oct 22, 2012

Garlic Soup Recipe
Oct 19, 2012

about Turner Syndrome
Oct 18, 2012

Carpal Tunnel Syndrome
Oct 18, 2012

The Ancient Art of Thai Yoga Massage
Oct 18, 2012

Bursitis
Oct 18, 2012

Repetitive Motion Injuries
Oct 18, 2012

Psychological Healing Through Touch R...
Oct 9, 2012

Pulmonary Valve Stenosis (PVS)
Oct 9, 2012

Mitral Valve Prolapse (MVP)
Oct 9, 2012

The Esalen Approach
Oct 3, 2012

Atrial Septal Defect
Oct 3, 2012

Heart Valve Diseases
Oct 3, 2012

Cardiac Catheterization
Oct 3, 2012

Molds and Mold Spores
Oct 3, 2012

The World vs Monsanto
Oct 3, 2012

High Temps Lead to High Fall Allergies
Oct 1, 2012

about Scoliosis
Oct 1, 2012

Kawasaki Disease
Oct 1, 2012

Fanconi Anemia
Oct 1, 2012

Haemachromatosis
Oct 1, 2012

The High Health Costs of High Heels
Sep 27, 2012

Where Do Warts Come From?
Sep 27, 2012

Is Weight Loss Surgery The Right Choice?
Sep 27, 2012

The Complete Cost of Obesity
Sep 27, 2012

The Healing Happiness of Hot Stone Massa...
Sep 27, 2012

The Reasons for Reflexology
Sep 25, 2012

Cold Season Is Coming
Sep 25, 2012

Pink Slime Strikes Back!
Sep 18, 2012

Epidemic or pandemic?
Sep 17, 2012

Bronchitis
Sep 17, 2012

Emphysema
Sep 17, 2012

Pneumonia
Sep 17, 2012

Living with Type 1 Diabetes
Sep 17, 2012

Did you get your flu shot?
Sep 17, 2012

Avoiding back pain through proper body m...
Sep 17, 2012

Dealing with back pain
Sep 17, 2012

about Cat Scratch Fever disease
Sep 17, 2012

Fevers aren’t always a bad thing
Sep 17, 2012

The stomach flu
Sep 17, 2012

In love with massage therapy or massage ...
Sep 17, 2012

The healing power of Shiatsu
Sep 17, 2012

100 lb weight loss journey motivates tra...
Sep 13, 2012

Stanford organic food study – a pe...
Sep 11, 2012

Massage myths and misconceptions
Sep 10, 2012

Norovirus
Sep 10, 2012

Diptheria
Sep 10, 2012

about Tetanus
Sep 10, 2012

Meniere’s Disease
Sep 10, 2012

Reye’s Syndrome
Sep 10, 2012

about Croup
Sep 10, 2012

The return of the measles
Sep 10, 2012

about Amyloidosis
Sep 10, 2012

Ear Infections
Sep 10, 2012

Meningitis
Sep 10, 2012

about Encephalitis
Sep 10, 2012

Worst Year Yet For West Nile Virus
Sep 10, 2012

In defense of Lance Armstrong
Sep 6, 2012

Agent Orange sickness
Sep 6, 2012

Tourette Syndrome
Sep 6, 2012

New York I-STOPs prescription drug abuse
Aug 28, 2012

Medulloblastoma
Aug 27, 2012

Brain tumors
Aug 27, 2012

Pancreatitis
Aug 27, 2012

Polycystic Kidney Disease
Aug 27, 2012

Fuel your workouts to the max
Aug 27, 2012

Why too much cholesterol is bad
Aug 21, 2012

Hypertension
Aug 21, 2012

How video games ruin outside playtime
Aug 21, 2012

Gout
Aug 18, 2012

Swimmer’s Ear
Aug 18, 2012

Athlete’s Foot
Aug 18, 2012

Swedish Massage
Aug 18, 2012

Blood Poisoning
Aug 17, 2012

Do you need to start exercising?
Aug 17, 2012

Appendicitis
Aug 17, 2012

Mahi Mahi With Broccoli & Pineapple
Aug 16, 2012

Wilson’s Disease
Aug 15, 2012

Things to keep in mind before your next ...
Aug 15, 2012

What to expect from a massage session
Aug 15, 2012

The Glory of The Games
Aug 13, 2012

5 tips on finding the right massage ther...
Aug 13, 2012

Cirrhosis
Aug 13, 2012

Alcoholism and Alcohol Abuse
Aug 13, 2012

Erectile Dysfunction
Aug 13, 2012

Back to the Breast: Promoting breastfeed...
Aug 10, 2012

Prostrate Cancer
Aug 9, 2012

Toxic Shock Syndrome
Aug 9, 2012

Diabetes Mellitus
Aug 9, 2012

The many worlds of massage therapy
Aug 7, 2012

Pelvic Inflammatory Disease
Aug 6, 2012

Endometriosis
Aug 6, 2012

Understanding strokes
Aug 6, 2012

Marfan Syndrome
Aug 6, 2012

DVTs and VTEs
Aug 6, 2012

Massage: The path to natural well being
Aug 6, 2012

A No Excuse 15 Minute Workout
Aug 3, 2012

Facts On Health
Jul 31, 2012

What is an aneurysm?
Jul 26, 2012

Understanding heart attacks
Jul 26, 2012

Dealing with food poisoning
Jul 26, 2012

Sprains, Strains and Tears
Jul 26, 2012

A few small changes to change your life
Jul 25, 2012

Spinal Cord Injury
Jul 24, 2012

head Concussion issues
Jul 24, 2012

Psoriasis autoimmune disorder issues
Jul 24, 2012

Chagas Disease
Jul 24, 2012

Osteomyelitis
Jul 24, 2012

Alternative treatments for ParkinsonR...
Jul 24, 2012

Panic Disorder
Jul 24, 2012

Obsessive Compulsive Disorder
Jul 24, 2012

6 Reasons For You To Lift Weights
Jul 18, 2012

The Incredible (in)Edible Egg Bill
Jul 12, 2012

Breakout Win – Michelle Ulibarri t...
Jul 12, 2012

Schizophrenia
Jul 12, 2012

E Coli virus
Jul 12, 2012

Parkinson’s Disease
Jul 12, 2012

Treating ALS with Noni
Jul 12, 2012

Treating osteogenesis imperfecta (OI) wi...
Jul 11, 2012

Pet therapy: how Fido and Whiskers make ...
Jul 11, 2012

Grief of saying good-bye to a loved one
Jul 11, 2012

Cervical Cancer
Jul 11, 2012

Epstein-Barr virus
Jul 11, 2012

Hodgkin’s disease
Jul 11, 2012

Guillain-Barre Syndrome (GBS)
Jun 28, 2012

Bone marrow transplants
Jun 28, 2012

Sickle Cell Anemia
Jun 28, 2012

Natasha Lowe – Soldier, model, mot...
Jun 28, 2012

Tuna Sandwich recipe
Jun 26, 2012

Smoked Chicken Salad Sandwich recipe
Jun 25, 2012

Fanconi anemia
Jun 25, 2012

Endometrial Cancer, cancer of the uterus
Jun 25, 2012

Huntington’s Disease
Jun 25, 2012

Phenylketonuria
Jun 25, 2012

Metabolic disorders and syndromes
Jun 25, 2012

Take the good with the bad: The Sanders ...
Jun 22, 2012

Seizure Disorders
Jun 21, 2012

Breast Cancer
Jun 21, 2012

Myelodysplastic syndromes
Jun 21, 2012

Ovarian Cancer
Jun 21, 2012

Lynch Syndrome
Jun 21, 2012

Hirschsprung’s disease
Jun 21, 2012

Living with an ostomy
Jun 21, 2012

Diverticulosis Disease
Jun 21, 2012

Colon Cancer
Jun 18, 2012

HIV/AIDS
Jun 18, 2012

Leukemia
Jun 18, 2012

Tuberculosis making a comeback
Jun 18, 2012

Addison’s Disease
Jun 18, 2012

Caring for a child with Down Syndrome
Jun 15, 2012

Down Syndrome
Jun 15, 2012

Crohn’s Disease
Jun 15, 2012

Osteoporosis
Jun 15, 2012

Osteoarthritis
Jun 15, 2012

Mesothelioma
Jun 15, 2012

Artificial Sweetener Disease Anyone?
Jun 12, 2012

The Zombie Apocalypse and other drugs
Jun 1, 2012

Dyslexia
May 31, 2012

Sexually transmitted diseases
May 31, 2012

Trapped inside Agoraphobia
May 31, 2012

Treat Cerebral Palsy naturally
May 31, 2012

Natural and alternative treatments for C...
May 31, 2012

ALS – Lou Gehrig’s Disease
May 30, 2012

Cystic Fibrosis
May 30, 2012

Spilt milk, supplements and party politi...
May 29, 2012

Cerebral Palsy
May 25, 2012

Learning disabilities vs learning disord...
May 25, 2012

A look at Glaucoma
May 15, 2012

Understanding Cataracts
May 15, 2012

Melanoma: the dangerous skin cancer
May 15, 2012

Hashimoto’s disease
May 15, 2012

Sunless Tanning is not safe!
May 15, 2012

Dangers of sun and bed tans
May 15, 2012

The Real deal on Raw Organic Milk
May 15, 2012

Simple pleasures in fitness diet
May 11, 2012

Building a bodacious booty
May 11, 2012

The ABCs of AMD (Adult Macular Degenerat...
May 11, 2012

The dangers of Munchausen’s Syndro...
May 11, 2012

Ease your migraine pain naturally
May 11, 2012

Understanding Migraine headaches
May 8, 2012

Manage Chronic Fatigue the natural way
May 8, 2012

Cure your headache
May 8, 2012

Dealing with Chronic Fatigue
May 8, 2012

Sciatica defined
May 3, 2012

Shingles – the adult chicken pox
May 3, 2012

A quick tutorial on Hepatitis
May 3, 2012

Alternative treatments for Multiple scle...
May 3, 2012

State regulators step up attack on food ...
May 2, 2012

About Multiple Sclerosis
May 2, 2012

Unraveling the mysterious Myasthenia Gra...
May 2, 2012

Learning about Lupus
May 2, 2012

What are autoimmune diseases?
May 2, 2012

New Wave of Polio Across India Caused by...
Apr 30, 2012

Understanding Fibromyalgia
Apr 26, 2012

Helping Alzheimer’s the natural wa...
Apr 26, 2012

Caring for someone with Alzheimer’...
Apr 25, 2012

Global Ban Called On Bee Killing Pestici...
Apr 23, 2012

Pasta e Fagioli recipe
Apr 19, 2012

Vegan Carrot Soup recipe
Apr 19, 2012

Oatmeal Strawberry Breakfast, Lunch or L...
Apr 19, 2012

Sweet Potato Baked Sticks recipe
Apr 19, 2012

Identifying Alzheimer’s
Apr 18, 2012

Noni fruit your immune system
Apr 18, 2012

Understanding the immune system
Apr 17, 2012

Stay fit as a senior
Apr 17, 2012

Walk your way to better health
Apr 17, 2012

Stay in shape with low impact exercise
Apr 17, 2012

Enhancing epilepsy treatment with altern...
Apr 17, 2012

Video Games are bad for you
Apr 16, 2012

Debunking the myths about epilepsy
Apr 11, 2012

Get to the point with acupuncture
Apr 11, 2012

Treat your allergies naturally
Apr 11, 2012

Chicken Contains Cancer Causing Arsenic
Apr 9, 2012

Three principles of Asana
Apr 9, 2012

Recognizing Lyme disease
Apr 9, 2012

Avoid getting ticks
Apr 9, 2012

Dealing with bullies and the bullied
Apr 9, 2012

Recognizing the signs of bipolar disorde...
Apr 9, 2012

Children and PTSD
Apr 9, 2012

The fly on our nose
Apr 5, 2012

Breaking the addiction to toxic sugars
Apr 2, 2012

A meditation on meditation
Apr 2, 2012

What you should know about skin cancer
Apr 2, 2012

Yoga basics you should know
Mar 30, 2012

Teas, tinctures and compresses
Mar 29, 2012

wise Advise for asthma sufferers
Mar 29, 2012

Study says prepare for the end of male p...
Mar 28, 2012

Wonderful Common cures from your spice r...
Mar 28, 2012

A brief history of herbalism
Mar 28, 2012

What is Lieshmaniasis?
Mar 28, 2012

Simply Kendi part 5
Mar 16, 2012

Simply Kendi part 4
Mar 16, 2012

Simply Kendi part 3
Mar 16, 2012

Simply Kendi part 2
Mar 16, 2012

The cancer-fighting properties of the Gr...
Mar 15, 2012

Defining alternative medicine
Mar 14, 2012

Finding balance between ideal fitness an...
Mar 13, 2012

The dangers of heat stroke
Mar 13, 2012

Safely soak up the sun without getting b...
Mar 13, 2012

Dealing with whooping cough
Mar 13, 2012

The case for vaccination
Mar 13, 2012

Preparing and caring for organ transplan...
Mar 13, 2012

Get ready for chicken pox season
Mar 13, 2012

The slimy business at the USDA
Mar 12, 2012

Medical realities of the very poor
Mar 7, 2012

Treat fatigue along with pain when deali...
Mar 6, 2012

The difficulties of teenage pregnancy
Mar 6, 2012

Don’t let fear impede treating you...
Mar 5, 2012

Cholesterol Drug Memory Loss and Diabete...
Mar 5, 2012

Beware intestinal parasites
Mar 2, 2012

Extreme developmental hazards of child n...
Mar 2, 2012

Noni juice fights depression
Mar 2, 2012

The ancient wisdom of Ayruveda
Mar 2, 2012

Exotic, nutritious foods
Mar 2, 2012

Cauliflower Crust Pizza recipe by Fitnes...
Mar 2, 2012

Help your child through his ADHD
Mar 1, 2012

Vegetarian Chili recipe
Feb 27, 2012

Pasteurized milk linked to cancer report...
Feb 27, 2012

Canadian Bacon Emmentaler Mushroom Fritt...
Feb 23, 2012

Lime Thyme Bars Recipe-
Feb 23, 2012

Magic pills, the FDA and curing the comm...
Feb 23, 2012

Weight loss drug near FDA approval
Feb 23, 2012

Ways to treat migraine
Feb 22, 2012

Real men don’t buy girls
Feb 15, 2012

farm-to-fork
Feb 13, 2012

get rid yourself of muscle cramps for go...
Feb 9, 2012

Sleep those extra pounds off
Feb 8, 2012

Remember, your doctor works for you
Feb 8, 2012

Living with Rhuematoid Arthritis (RA)
Feb 6, 2012

Manage your pain your way
Feb 2, 2012

4 easy ways to get rid of back pain
Jan 31, 2012

French Onion Soup recipe
Jan 27, 2012

Caribbean Salmon Salad recipe
Jan 26, 2012

Warm Filet Mignon Salad recipe
Jan 26, 2012

Chicken Mango Salad recipe
Jan 25, 2012

Sesame Chicken Salad recipe
Jan 25, 2012

What foods cause arthritis pain
Jan 20, 2012

Olive oil is great for your health
Jan 17, 2012

High sodium content for fast food burger...
Jan 16, 2012

The Healthy Power of Bee’s
Jan 10, 2012

Improve your memory by exercising and ea...
Jan 8, 2012

Salt is good for you
Jan 7, 2012

be Careful about that next fast food tha...
Jan 7, 2012

3 Tips for a clean and glowing face
Jan 5, 2012

Ease your pain with music
Dec 28, 2011

Organ Damage and Failure Linked To Monsa...
Dec 27, 2011

Tips on losing that extra Christmas weig...
Dec 26, 2011

Great fitness gifts for Christmas
Dec 21, 2011

Kidney stones: who is at risk
Dec 19, 2011

Lift your mood with Food
Dec 15, 2011

FDA bans HCG
Dec 6, 2011

Healthy Eating Tips for kids
Dec 3, 2011

Fad diets to Avoid
Dec 2, 2011

Turkey Leftover Quesadillas
Nov 27, 2011

More complaints in the wake of Jerry San...
Nov 27, 2011

Tasty and Cheesy Omelets recipe
Nov 26, 2011

Fluffy Pancakes recipe
Nov 26, 2011

A new obesity fat cell “killing” drug ca...
Nov 26, 2011

Keeping your colon constipation and canc...
Nov 25, 2011

Rule over New Food Bacteria by China’s G...
Nov 25, 2011

Things to consider before your vasectomy
Nov 21, 2011

Independent investigation sought by Penn...
Nov 19, 2011

Planning a Healthy Holiday Vacation? Her...
Nov 15, 2011

How to Alleviate Knee Pain
Nov 2, 2011

Christmas Classical Pumpkin Pie
Nov 2, 2011

How to tell if your kid is overweight an...
Nov 1, 2011

Facts on Fiber
Oct 27, 2011

Reflexology Benefits
Oct 27, 2011

Workouts for those on the go!
Oct 27, 2011

Synthetic and Bioidentical Teststerone
Oct 27, 2011

Maximize your Delts
Oct 27, 2011

The Making of a Man
Oct 27, 2011

Facts on Hypothyroidism
Oct 20, 2011

The Scoop on Kefir
Oct 19, 2011

The Power of Anti-Oxidants
Oct 18, 2011

Shrimp and Crabmeat Cocktail with Kumqua...
Oct 18, 2011

Tuna Salad Sublicilous
Oct 17, 2011

Tzatziki with Pita Chips
Oct 17, 2011

Raspberry-Glazed Chicken with Spinach Sa...
Oct 14, 2011

Parmesan Rosemary and Onion Crusted Lamb...
Oct 14, 2011

Tuna Puttanesca with Fettuccini
Oct 14, 2011

Homemade And Scrumptious Gravy
Oct 14, 2011

Mustard Herb Crusted Eye of Round Roast
Oct 14, 2011

Mom’s Meatloaf Recipe
Oct 13, 2011

Spicy Beef and Snap Peas with Rice
Oct 13, 2011

Low Cal Poached Tuna Steak Meal
Oct 13, 2011

Low Calorie Szechwan Shrimp
Oct 12, 2011

Mediterranean Salad Dressing
Oct 12, 2011

Grilled Garlic Chicken and Tomato Salad
Oct 12, 2011

Dr Gary Bellman, M.D.
Oct 12, 2011

Fettuccine Low Cal Alfredo
Oct 9, 2011

World Depopulation Actions by the United...
Oct 6, 2011

Positive vibes for feeling great
Oct 4, 2011

Is your hair thinning out on top or on t...
Oct 1, 2011

The Scoop on CTS-Carpal Tunnel Syndrome
Sep 30, 2011

Getting our Teenagers to Always Eat Righ...
Sep 30, 2011

How Much Water to Drink?
Sep 27, 2011

Low Calorie Balsamic Vinaigrette
Sep 25, 2011

Lightly Pan Fried Whole Mackerel
Sep 25, 2011

Virgin Cuban Mojito
Sep 25, 2011

Healthy Seafood Pizza Recipe
Sep 25, 2011

Homemade Pesto Recipe
Sep 25, 2011

Eat your way to a Healthy Recovery after...
Sep 24, 2011

Tips to Maintaining a Healthy Kid
Sep 24, 2011

How to Recognize High Blood Pressure Sym...
Sep 24, 2011

By Reducing your Sodium Intake you can R...
Sep 24, 2011

3 Ways to Prevent Heart Disease
Sep 23, 2011

Tips on Managing Prostate Cancer
Sep 22, 2011

Tips to Preventing Prostate Cancer
Sep 20, 2011

Helpful Hints for Diabetics
Sep 20, 2011

The Wonders of Basil for Diabetes
Sep 20, 2011

Health Benefits of Spirulina
Sep 19, 2011

Feed Your Eyes for better vision
Sep 18, 2011

Blueberries Great for Students Memory
Sep 18, 2011

Good Handwriting is Healthy
Sep 17, 2011

How to Measure Your Workout Intensity
Sep 17, 2011

Super Brain Foods for Your Super Kids
Sep 16, 2011

Great Snacks for Kids
Sep 15, 2011

Fun Ways to Get Your Kids to Exercise
Sep 15, 2011

3 Cool ways to get your kids to eat thei...
Sep 15, 2011

Your Calorie Intake Can Affect Your Mood
Sep 15, 2011

5 Tips To Getting a Great Night’s Seep
Sep 15, 2011

The New Superfood called Kañiwa
Sep 15, 2011

Quick Steps to Weight Gain
Sep 15, 2011

Lose Weight by Chewing
Sep 15, 2011

Too Much Weight Can Cause Diabetes
Sep 15, 2011

Key to a Happy, Long and Rewarding Sex L...
Sep 15, 2011

Don’t Let That Salad Ruin your Diet
Sep 15, 2011

Digestive Enzyme Facts
Sep 15, 2011

Key to happy, long and rewarding Sex Lif...
Sep 15, 2011

Amino acids and your workout
Sep 6, 2011

The wonderful tomato
Sep 6, 2011

WARNING: Don’t eat while angry
Sep 6, 2011

Three reasons to join a gym
Sep 6, 2011

How music helps you loose weight
Sep 6, 2011

Five cool health facts
Sep 6, 2011

The good news on peppermint
Sep 6, 2011

Three fun ways to loose weight
Sep 6, 2011

Making healthy lunches for your kid
Sep 6, 2011

Drink tea for better health
Sep 6, 2011

Hot sauce: a cure for cancer?
Sep 6, 2011

Grapefruits are great for your gums
Sep 6, 2011

Olive oil can reduce cancer risks
Sep 6, 2011

Tips to flatten your tummy
Sep 6, 2011

Pico de Gallo Salsa
Sep 2, 2011

Healthy and Light Stir Fry
Sep 2, 2011

Bloody Mary Shrimp Cocktail
Sep 2, 2011

Roasted and Healthy Peanuts
Sep 2, 2011

T-Cell therapy maybe treatment for leuke...
Aug 30, 2011

How aging effects the brain
Aug 30, 2011

Three quick bites for a healthy diet
Aug 30, 2011

African cactus suppresses hunger
Aug 30, 2011

High fiber diet reduces risk of heart di...
Aug 30, 2011

Berry good news about your health
Aug 30, 2011

Those Clothes your Wearing may be Danger...
Aug 29, 2011

Water – The key to good health
Aug 29, 2011

Hypogonadism – deadly low testoste...
Aug 29, 2011

How low testosterone affects your mood, ...
Aug 29, 2011

How excessive drinking affects your diet
Aug 29, 2011

The greatness of Wheatgrass
Aug 29, 2011

Natural ways to boost your testosterone
Aug 29, 2011

Garlic Health Benefits
Aug 29, 2011

Three reasons to drink wine
Aug 29, 2011

Three way to avoid diabetes
Aug 29, 2011

Five drinks that help you loose weight
Aug 29, 2011

Converting bad white fat to good brown f...
Aug 29, 2011

How Mother Nature clues us into healthy ...
Aug 29, 2011

Four ways to a flat stomach
Aug 29, 2011

T-cells can fight leukemia
Aug 29, 2011

Better sex through yoga
Aug 29, 2011

Guide to a healthy prostate
Aug 29, 2011

Color therapy diet
Aug 29, 2011

Hearty foods to help the heart
Aug 29, 2011

The Truth about Monsanto
Aug 29, 2011

Federal Raid at Raw Food Store
Aug 29, 2011

10 fitness tips for students
Aug 29, 2011

The spots of age
Aug 29, 2011

A proper diet’s effect on memory
Aug 29, 2011

The wonders of Garlic
Aug 29, 2011

Maintaining healthy eyes
Aug 29, 2011

Dealing with Carpal Tunnel Syndrome
Aug 29, 2011

The ABCs of minerals
Aug 29, 2011

Health benefits of Phytochemicals
Aug 29, 2011

The Fats That are Good For You
Aug 29, 2011

SC College to Require Fitness Assesments
Aug 29, 2011

Watermelon Strawberry Breakfast Smoothie
Aug 25, 2011

Blueberry Peanut Butter Frozen Yogurt Sm...
Aug 25, 2011

Berry Frozen Yogurt Smoothie
Aug 25, 2011

Healthy Garlic Soup
Aug 24, 2011

Oriental Fresh Stir Fry
Aug 19, 2011

Baked Chicken with Vegetables
Aug 16, 2011

Bacon Lettuce and Tomato Toasted Sub wit...
Aug 15, 2011

Kick-starting proper kidney function
Aug 10, 2011

The power of breathing
Aug 10, 2011

Laughter, the cure all
Aug 10, 2011

Dealing with ADHD through diet
Aug 10, 2011

Mate tea – wonder drink from South...
Aug 10, 2011

The truth about MSG
Aug 10, 2011

How obesity effects fertility
Aug 10, 2011

Easy tips to stay in shape
Aug 10, 2011

How TV and video games effect a child...
Aug 10, 2011

Six fun facts about health
Aug 10, 2011

Dangers of deprived sleep
Aug 10, 2011

Gene linked to longevity
Aug 10, 2011

Raw Milk Suppliers Raided
Aug 10, 2011

Carrot and Pineapple Smoothie
Aug 7, 2011

Kiwi Smoothie
Aug 7, 2011

Chocolate Peanut Butter Smoothie Recipe
Aug 7, 2011

Berry Brunch Smoothie
Aug 7, 2011

Granola Smoothie Crunch
Aug 7, 2011

Pizza
Aug 5, 2011

Quick Pizza Dough
Aug 5, 2011

Pizza Marinara Sauce, Homemade!
Aug 4, 2011

Pineapple and Mango Kebabs
Aug 4, 2011

Zucchini and Chickpeas Appetizer
Aug 4, 2011

Nutrients your child may be missing
Aug 4, 2011

The cancer risks in carpets
Aug 4, 2011

Healthy tips for eating out
Aug 4, 2011

Controlling stress
Aug 4, 2011

Healing power of laughter
Aug 4, 2011

The problem with “health” dr...
Aug 4, 2011

The good news on strawberries
Aug 4, 2011

Shrimp Tacos
Aug 3, 2011

Low calorie Onion Soup
Aug 3, 2011

Spinach and Ricotta stuffed Portobello m...
Aug 3, 2011

Five easy tips to avoid aging your skin
Aug 1, 2011

Five ways soda effects your health
Aug 1, 2011

Chicken Cole Slaw Asian Style
Jul 31, 2011

Hearty Healthy Hot Beef Stew
Jul 31, 2011

Mystical Mango Smoothie
Jul 28, 2011

Bloody Mary a la shrimp
Jul 28, 2011

The benefits of soy milk
Jul 27, 2011

Get your metabolism healthy
Jul 27, 2011

10 easy tips to burning 500 calories a d...
Jul 27, 2011

FDA says Fritos healthier than walnuts
Jul 27, 2011

Tuna Tartare
Jul 27, 2011

Roasted Red Pepper Crab Soup
Jul 27, 2011

Study finds soluble fiber helps burn bel...
Jul 25, 2011

10 easy tips for better fitness
Jul 25, 2011

Sea salts and naps slow aging
Jul 25, 2011

The wonders of wheatgrass
Jul 25, 2011

Peanut Butter-and-Blueberry Jam Sandwich...
Jul 23, 2011

Spinach-Cheese and Smoked Salmon Omelet
Jul 23, 2011

Smoked Turkey Reuben Cranberry Sandwich
Jul 23, 2011

Chicken and Vegetable Stir-Fry with Long...
Jul 23, 2011

Berries help fight Parkinson’s new...
Jul 20, 2011

FDA’s War on Dietary Supplements
Jul 20, 2011

Top ten health problems that cause death
Jul 20, 2011

Woman Threatened for Growing Vegetables ...
Jul 20, 2011

Toxic dangers in high fructose corn syru...
Jul 20, 2011

Improving posture through exercise
Jul 20, 2011

The deal with Superfoods
Jul 20, 2011

Coconut Smoothie Recipe
Jul 20, 2011

Blueberry Peanut Butter Smoothie
Jul 20, 2011

Fresh Papaya and Zapote Smoothie
Jul 20, 2011

Homemade Apple Pie
Jul 20, 2011

Grilled Sirloin Tostadas
Jul 20, 2011

Tri colored fettuccini with fresh herbs
Jul 20, 2011

Roasted Red Pepper Salad
Jul 20, 2011

Alaskan Salmon marinated in a Cilantro l...
Jul 20, 2011

Are You a Guinea Pig in the World’...
Jan 24, 2010

Whats going on with the water you drink
Aug 29, 2009

Frank Zane
Jul 14, 2009

Calorie Counter
Jul 7, 2009

CDC
Jul 7, 2009

Contact Us
Jun 23, 2009

L. Gardiner
Jun 17, 2009

Charities
Jun 4, 2009

Doctors
Jun 4, 2009

Diets
Jun 4, 2009

Female Models
Jun 3, 2009

Male BodyBuilders
Jun 3, 2009

Links
Jun 1, 2009

Gyms Finder
Jun 1, 2009

FDA
Jun 1, 2009

Food Facts
Jun 1, 2009

RDA and DRI
Jun 1, 2009

Friends
Jun 1, 2009

Glycemic Index
Jun 1, 2009

Fast food Facts
Jun 1, 2009

Food Pyramid
Jun 1, 2009

Sponsors
Jun 1, 2009

Events
Jun 1, 2009

Sports Associations
Jun 1, 2009

Trainers
Jun 1, 2009

Weight Loss Support
Jun 1, 2009

Health & Nutrition Books
Apr 15, 2009

Alternative Medicine Books
Mar 22, 2009

Anti-Aging Books
Mar 22, 2009

BodyBuilding Books
Mar 22, 2009

Diet Books
Mar 22, 2009

Fitness Training Books
Mar 22, 2009

Steroid Books
Mar 22, 2009

Weight loss Books
Mar 22, 2009

The Magic of Resveratrol
Mar 12, 2009

Establishing your overall health
Mar 12, 2009

Easy Home Exercises
Mar 12, 2009

Basic dieting facts
Mar 12, 2009

Effects of Exercise on Diabetes
Mar 12, 2009

Bringing Exercise Indoors
Mar 12, 2009

Bigger isn’t better: Cigar secondhand sm...
Mar 12, 2009

South Beach Diet Book Review
Mar 12, 2009

Dealing with bad breath
Mar 12, 2009

Recognizing Severe Depression
Mar 12, 2009

Acai Berry and Weight Loss
Mar 12, 2009

Caring for your Colon
Mar 12, 2009

Pros and Cons of LASIK Surgery
Mar 12, 2009

The Deal with the Raw Diet
Mar 12, 2009

Staying Honest with your Doctor
Mar 12, 2009

Muscle Building Tips
Mar 5, 2009

Building a Gym at Home
Mar 5, 2009

The Secret To Six-pack Abs
Mar 5, 2009

Tips to preventing wrinkles
Mar 5, 2009

Buying the right protein supplement
Mar 4, 2009

Using the treadmill
Mar 4, 2009

Easy hair loss cures
Feb 18, 2009

Understanding Excessive Sweating
Feb 18, 2009

Reviewing the Revolution: A look at the ...
Feb 17, 2009

Starting your exercise routine
Feb 8, 2009
Nutrition
LatestCelery Is Not An Empty Food
by Kimberly Allen, RN Frequently celery is thought of as just one of those empty foods you eat...